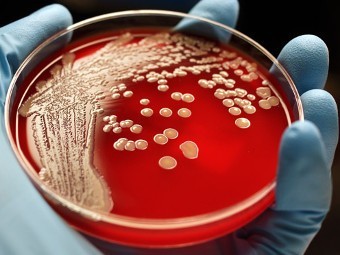

да
-
-
# 27 апреля 2015 21:04
Это нормально получить жёлтую карточку через 24 дня ?
Срок давности за совершённое преступление такого рода существует ?Будьте хорошими людьми настолько, насколько это возможно. -
# 27 апреля 2015 21:06
Yuna, и через несколько лет давали
 видел как-то в баяне ) потом правда пост был удален
видел как-то в баяне ) потом правда пост был удален  Реформы у нас что чирей — никогда не знаешь, в каком месте выползет в следующий раз (с) Хрюн Моржов.
Реформы у нас что чирей — никогда не знаешь, в каком месте выползет в следующий раз (с) Хрюн Моржов. -
# 27 апреля 2015 21:09 Редактировалось Bierman, 1 раз.
Yuna:
Это нормально получить жёлтую карточку через 24 дня ?
какие мелочи
 были случаи когда карты прилетали почти через 10 лет...Nu’ det tid til druk og hor!
были случаи когда карты прилетали почти через 10 лет...Nu’ det tid til druk og hor! -
Будьте хорошими людьми настолько, насколько это возможно.
-
Реформы у нас что чирей — никогда не знаешь, в каком месте выползет в следующий раз (с) Хрюн Моржов.
-
# 28 апреля 2015 19:16
Если бактерии складывать в кучу, какое количество нужно бактерий, чтобы они стали видны человеческому глазу без оптических и электронных устройств увеличения? Можно ли собрать куб из одних только бактерий размерностью 3*3*3 см?
Всё хорошее зреет долго. Каждый из вас прав! Прав, со своей колокольни. -
# 28 апреля 2015 22:20
Смертья:
Если бактерии складывать в кучу, какое количество нужно бактерий, чтобы они стали видны человеческому глазу без оптических и электронных устройств увеличения? Можно ли собрать куб из одних только бактерий размерностью 3*3*3 см?
Сильно зависит от самих бактерий, бо по сообщениям натуралистов бывают всякие намибийские серные жемчужины, которые достигают размеров до 3/4 мм в поперечнике -- можно одну глазом разглядеть, особенно близорукому. Не гуляйте по намибийскому шельфу спьяну!
-
# 28 апреля 2015 23:16
sepuka,
 не употребляю.
Добавлено спустя 10 минут 38 секунд
не употребляю.
Добавлено спустя 10 минут 38 секундsepuka, Интересуют те, которые в среднем размерами 0,5—5 мкм.
Смертья:
чтобы они стали видны человеческому глазу без оптических и электронных устройств увеличения
Т.е. речь шла о тех, которые изначально не видны.
Благодарю за информацию sepuka.Всё хорошее зреет долго. Каждый из вас прав! Прав, со своей колокольни. -
-
-
-
# 29 апреля 2015 12:37
В каком банке лучше открывать ПайПэл и можно ли потом его обналичивать? Кто знает...
Hammock - Holding Your Absence -
Неизвестный кот Neophyte PosterофлайнНеизвестный кот Neophyte Poster
0
пользователь #1623878Город:0# 29 апреля 2015 12:42прилетают друзья из Сингапура и США.....

что лучше попросить привезти оттуда в качестве подарков
моб.тел. , ноутбук , сигареты Мольборо ,........?
-
# 29 апреля 2015 13:23
lakke:
прилетают друзья из Сингапура и США.....
что лучше попросить привезти оттуда в качестве подарковвизы в эти страны...
[url=http://forum.onliner.by/viewtopic.php?t=1693836]Android Team[/url] -
IMHO by default.
-
# 29 апреля 2015 14:05
El-A:
В каком банке лучше открывать ПайПэл и можно ли потом его обналичивать? Кто знает...
онлайнер знает. есть целая ветка по палке.
-
Неизвестный кот Neophyte PosterофлайнНеизвестный кот Neophyte Poster
0
пользователь #1623878Город:0# 29 апреля 2015 17:44 Редактировалось Неизвестный кот, 1 раз.cколько в итоге денег стоит позвонить с домашнего телефона в компанию " Гипермаркет услуг - 124 " за 1 минуту разговора с диспетчерами-инвалидами ? ? ?
-
# 29 апреля 2015 17:58
lakke:
cколько в итоге денег стоит позвонить с домашнего телефона в компанию " Гипермаркет услуг - 124 " за 1 минуту разговора
3800 рублей.
На ошибках учатся, после ошибок - лечатся. -
Неизвестный кот Neophyte PosterофлайнНеизвестный кот Neophyte Poster
0
пользователь #1623878Город:0# 29 апреля 2015 18:40почему последняя страница ветки про депозиты не открывается ?
все остальные ветки на онлайнере - открываются без проблем....!
как назло ...или....? ? ?
.....сегодня-завтра банки ставки режут по депо и надо срочно делать закладки ....а доступа к свежей информации - нет.... ! (: